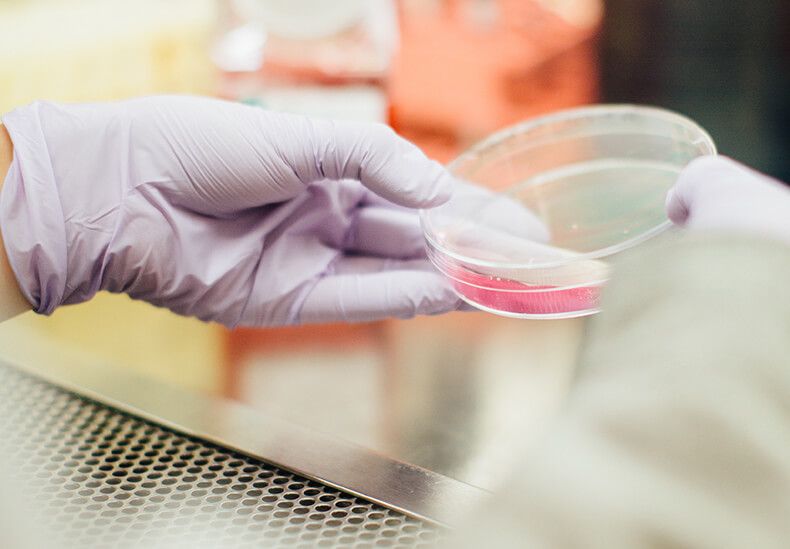

Beating breast cancer together
Inside the Nottingham Breast Cancer Research Centre
Since the Nottingham Breast Cancer Research Centre was established last March, 76 multi-disciplinary breast cancer researchers, clinical experts and breast cancer specialists have come together to improve our understanding of breast cancer and deliver new treatments.
More breast cancer experts are joining the Nottingham Breast Cancer Research Centre every week, and thanks to your support, we are working to find the next breast cancer research breakthrough sooner.
---
An update from Professor Stewart Martin
Director, Nottingham Breast Cancer Research Centre
Since we launched the Nottingham Breast Cancer Research Centre, we have remained focussed on our core research areas – stopping the spread, treating it right and detecting it early. 150 people are diagnosed with breast cancer every day in the UK, and we are dedicated to helping save and transform lives through research that has global impact.
Although our centre is in its infancy, the researchers who have joined have published nearly 900 breast cancer research papers in the last six years, which have been cited over 15,000 times by the international research community. By bringing together researchers, clinical academics and scientists, our aim is to create an environment for collaboration and partnership that will help create the next breakthroughs in breast cancer research.
This is an exciting time for the Nottingham Breast Cancer Research Centre. Thanks to your donations, we’re about to launch a pilot funding opportunity for three new breast cancer research projects. The grants we’re able to offer for this kind of novel research simply wouldn’t be possible without your support.
Supporting early-stage research
Pilot grants like these are hard to come by, but with your continued support, we hope to offer pilot grants for new projects in this way every year. Many funding bodies require evidence of results before awarding large grants, so your support means that our talented researchers have the chance to put forward their most innovative and creative projects with confidence.
"Your support means that our talented researchers have the chance to put forward their most innovative and creative projects with confidence."
Through exploring new ideas and supporting their early development, we will be able to quickly identify which projects have the greatest potential for impact. Our hope is that the research initiated within the Nottingham Breast Cancer Research Centre will go on to attract national and international funding, resulting in breakthroughs that will help the 55,000 women diagnosed with breast cancer every year in the UK.
New equipment gets results
As well as the new pilots, thanks to the generous support of the Brook family, and ‘Boobie Date’ supporters, we have been able to fund a new Hypoxy Lab for researchers to use within the Centre. This is a piece of equipment that allows us to monitor how cancer cells behave and respond to treatment in an environment that mimics the conditions inside a tumour. Although we've only been working with the Hypoxy Lab for a few months, the results our researchers are getting from it are absolutely astounding.
They’ve been testing new drugs on cancer cells in the areas of tumours that are known to be less responsive to treatment and cause the cancer to metastasise. We wouldn’t have been aware just how useful these drugs might be if we didn’t have this piece of kit. It’s making a tremendous difference to our work.
A new home for the centre
This year, we will be relocating to the new multi-million pound expansion of the Centre for Biomolecular Sciences at the University of Nottingham. We pride ourselves on our ability to collaborate on our research and these outstanding new facilities and co-location of our researchers will be a great step forward in the development of our research.
Thank you once again for your donations and fundraising efforts. We have been humbled by the level of support from people like you and across our local community. Your belief and backing is a great honour for everyone at the centre and we are all determined to do you proud.
A special invitation - meet our researchers
Saturday 15 June 2019
University Park
Meet our researchers and find out first-hand how your support is making a difference.
1 in 7 women in the UK will be diagnosed with breast cancer in their lifetime, which makes every penny you help us raise for the Nottingham Breast Cancer Research Centre incredibly valuable. Find out more about
our research and fundraising for us.
---
You may also be interested in:
The people behind the papers
Meet six researchers who work tirelessly behind the scenes to create a brighter future for children with brain tumours.
Living with 'scanxiety'
In the four years that he lived with a brain tumour, Sam White endured more than 25 distressing scans. His parents Mike and Pam, share how Sam's experience has helped transform the process for other children.